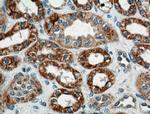
WNT4 Antibody in Immunohistochemistry (Paraffin) (IHC (P))
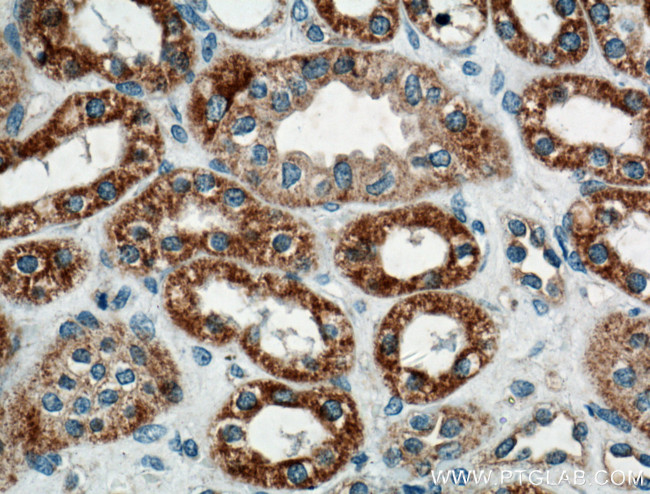
WNT4 Antibody in Immunohistochemistry (Paraffin) (IHC (P))

Search
Proteintech
WNT4 Polyclonal Antibody
{{$productOrderCtrl.translations['antibody.pdp.commerceCard.promotion.promotions']}}
{{$productOrderCtrl.translations['antibody.pdp.commerceCard.promotion.viewpromo']}}
{{$productOrderCtrl.translations['antibody.pdp.commerceCard.promotion.promocode']}}: {{promo.promoCode}} {{promo.promoTitle}} {{promo.promoDescription}}. {{$productOrderCtrl.translations['antibody.pdp.commerceCard.promotion.learnmore']}}

Please note: We are reviewing Western blot images included in the antibody testing data in our catalog, including those provided by third parties. Unless expressly labeled or annotated as “raw-unedited”, Western blot images included in the antibody testing data in our catalog may have been edited, optimized or otherwise adjusted for presentation.
产品信息
14371-1-AP
种属反应
宿主/亚型
分类
类型
抗原
偶联物
形式
浓度
规格
纯化类型
保存液
内含物
保存条件
运输条件
产品详细信息
Aliquoting is unnecessary for -20°C storage.
靶标信息
The WNT gene family consists of structurally related genes which encode secreted signaling proteins. These proteins have been implicated in oncogenesis and in several developmental processes, including regulation of cell fate and patterning during embryogenesis. This gene is a member of the WNT gene family, and is the first signaling molecule shown to influence the sex-determination cascade. It encodes a protein which shows 98% amino acid identity to the Wnt4 protein of mouse and rat. This gene and a nuclear receptor known to antagonize the testis-determining factor play a concerted role in both the control of female development and the prevention of testes formation. This gene and another two family members, WNT2 and WNT7B, may be associated with abnormal proliferation in breast tissue. Mutations in this gene can result in Rokitansky-Kuster-Hauser syndrome and in SERKAL syndrome.
仅用于科研。不用于诊断过程。未经明确授权不得转售。